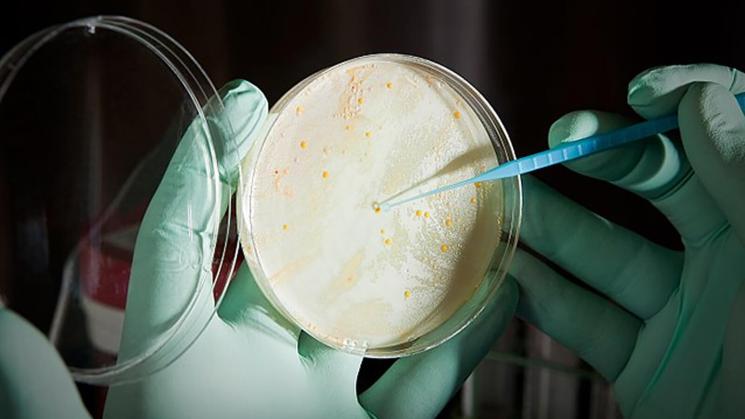
MICROORGANISMOS. Bacterias intrahospitalarias se pueden multiplicar en ambientes que no respetan protocolos.

MICROORGANISMOS. Bacterias intrahospitalarias se pueden multiplicar en ambientes que no respetan protocolos.
Al inicio de la pandemia, ante la creciente necesidad de oxígeno medicinal para los pacientes con covid-19 y en un contexto de escasez del insumo, muchas distribuidoras elevaron considerablemente sus precios. A contracorriente de esa tendencia, el empresario Mario Romero Pérez mantuvo estable el valor del medicamento en su distribuidora, ‘OxíRomeroGroup’, en el distrito limeño de San Juan de Miraflores. Esta acción le valió el apelativo de Ángel del Oxígeno.
En julio de 2020, Romero Pérez —que entonces tenía 62 años— se contagió de covid-19 y fue internado en la Unidad de Cuidados Intensivos (UCI) del Complejo Hospitalario Guillermo Kaelin, en el distrito de Villa María del Triunfo, Lima.
"Mi papá llega a tener un respirador artificial. En el cuarto y quinto día de hospitalización se le ve una mejora, pero adquirió una bacteria resistente de la unidad. Se le dio todo tipo de antibióticos. Pero, lamentablemente, la bacteria, ya no la covid, llegó a hacerle daño y falleció", contó a OjoPúblico su hijo Erick Romero Quinde, quien es médico neumólogo en el Hospital Víctor Ramos Guardia de Huaraz, en la región Áncash.
El Ángel del Oxígeno se contagió con la bacteria enterococo XDR (extremadamente resistente a medicamentos) y murió el 19 de julio de 2020. Como él, muchas otras personas adquieren infecciones en centros médicos, mientras son atendidas por otras enfermedades.
Lamentablemente, la bacteria, ya no la covid, llegó a hacerle daño y falleció", contó Erick Romero Quinde.
En 2018, según información a la que accedió OjoPúblico a través de un pedido sustentado en la Ley de Transparencia, se registraron 280 muertes asociadas al contagio de microorganismos en los establecimientos del Ministerio de Salud (Minsa).
En 2022, en cambio, los decesos llegaron a 1.702. En otras palabras, en los últimos cinco años, la cantidad de fallecimientos por esta causa aumentó en 507,86% en dichos centros de salud.
La cantidad de infectados también mostró una tendencia creciente. Según información de la sala situacional, en el primer semestre de 2018 —solo hay información para ese periodo de meses—, hubo 2.845 casos. En 2019 fueron 2.970 para el mismo lapso; en 2020 se reportaron 2.015, y, en 2021, 6.167 casos, siempre considerando la primera mitad del año. Aunque la información es limitada, muestra un aumento de 116,77%.
Este medio solicitó la misma información a EsSalud. Sin embargo, la entidad informó que no lleva un registro de las muertes relacionadas con infecciones adquiridas en sus centros de salud. En lo referido a contagios, EsSalud tampoco brindó la cantidad de casos, solo datos de las tasas de prevalencia de las enfermedades.
Infecciones asociadas a la atención en salud (IAAS)
Juan Carlos Celis Salinas, especialista de la Sociedad Peruana de Enfermedades Infecciosas y Tropicales, explica que los contagios con organismos intrahospitalarios son un problema mundial que tiene una proliferación silenciosa. "No es como la covid-19 [durante los primeros años de pandemia] en cuanto a la cantidad de casos, pero está afectando mucho a los países de ingresos medios y bajos, como el Perú", contó.
Estas afecciones ocurridas durante la atención en los servicios hospitalarios son nombradas como infecciones asociadas a la atención en salud (IAAS). La norma técnica del Minsa establece que para definir un caso de IAAS se debe cumplir con que el contagio ocurra durante la hospitalización o consulta ambulatoria, y no previo a una atención médica.
El Informe global sobre prevención y control de infecciones (IPC, por su sigla en inglés) de 2022, elaborado por la Organización Mundial de la Salud (OMS), detalla que "las IAAS se encuentran entre los eventos adversos más frecuentes que ocurren en el contexto de la prestación de servicios de salud. Estas infecciones, muchas de las cuales son causadas por organismos multirresistentes, dañan a los pacientes, visitantes y trabajadores, y suponen una carga importante para los sistemas de salud".
La OMS estima que, en los países de ingresos altos, siete de cada 100 pacientes atendidos en UCI adquirirán, al menos, una IAAS durante su estadía en el centro de salud. En los países de ingresos bajos y medianos, como Perú, el estimado se incrementa a 15 de cada 100 pacientes.

INFECCIONES. Organismos multirresistentes a antibióticos pueden dañar la salud de pacientes y trabajadores.
Foto: EsSalud.
El infectólogo Celis Salinas detalla que, por lo general, los pacientes con mayor riesgo son aquellos a los que se les ha realizado un proceso invasivo, como la colocación de sondas, respiradores, catéteres u operaciones.
Las afecciones causadas por las IAAS pueden clasificarse en cuatro grandes grupos: infecciones del torrente sanguíneo asociadas al uso de catéter venoso, neumonía asociada al uso de ventilador, infección del sitio quirúrgico e infecciones del tracto urinario asociadas al uso de catéter.
Entre 2020 y 2022, los microorganismos hospitalarios que más afectaron a los pacientes en los hospitales del país fueron las bacterias acinetobacter baumannii, klebsiella pneumoniae y pseudomonas aeruginosa. Algunas de ellas pueden permanecer en las superficies hasta por 90 días, y ser resistentes a algunos limpiadores.
César Munayco Escate, director del Centro Nacional de Epidemiología, Prevención y Control de Enfermedades (CDC) de Perú indicó a OjoPúblico que, en los distintos centros de salud, se tienen implementados protocolos para evitar o reducir la proliferación de estos microorganismos. “Si el sistema vigilancia detecta una bacteria, se hace la investigación, desinfección y el control de manera inmediata”, aclaró.
El especialista precisó que los microorganismos que se encuentran en superficies pueden ser controlados con una adecuada limpieza. Además, según explicó, cada hospital tiene un comité de control que se encarga, de forma exclusiva, de la vigilancia de las IAAS.
Deficiencias del sistema de salud aumentan el riesgo
Erick Romero Quinde perdió a su padre por la aparición de una bacteria intrahospitalaria, mientras era atendido por una infección de covid-19 en Lima. Como médico, le toca ver casos similares con pacientes del Hospital Víctor Ramos Guardia de Huaraz, un establecimiento de salud de segundo nivel, que carece de un laboratorio de microbiología equipado y espacio para aislar a las personas afectadas por IAAS.
El neumólogo indica que hay muchos factores estructurales que impiden poner un alto a estos contagios. "Los hospitales del Minsa y EsSalud, lamentablemente, tienen un mal diseño. Son infraestructuras antiguas, que se han preparado hace 50 años para una cantidad determinada de pacientes, y ahora tienen muchos más. Hay hacinamiento, y eso genera que el aire se contamine", dijo.
Las bacterias intrahospitalarias se encuentran en distintos ambientes de los centros de salud y pueden llegar a los pacientes a través de las manos del personal sanitario que no siguió un protocolo adecuado para introducir una sonda. También pueden estar adheridos al instrumental médico o contagiarse entre pacientes que se encuentran muy cerca entre sí.
El informe global de la OMS estima que hasta el 70% de las IAAS pueden prevenirse ampliando una serie de intervenciones eficaces de prevención y control de infecciones. Además, la higiene ambiental y de manos en los establecimientos de salud pueden reducir hasta el 40% el riesgo de morir por infecciones con patógenos altamente resistentes, así como las complicaciones a largo plazo.
La OMS estima que hasta el 70% de las IAAS pueden prevenirse".
En esa línea, un protocolo riguroso puede reducir notablemente los casos que se vienen reportando en el ámbito nacional. Sin embargo, la situación de los establecimientos de salud de Perú no es la más óptima. Por el contrario, puede ser un factor que permita la proliferación de estos patógenos, indicó el neumólogo Romero Quinde.
El reporte Análisis de Situación de Salud del Perú 2021, elaborado por el Minsa, muestra que, en el primer nivel de atención, el 97% de las instituciones prestadoras de servicios de salud tenían condiciones inadecuadas de infraestructura y equipamiento.
En el segundo y tercer nivel, que corresponde a hospitales y clínicas con más especialidades, el porcentaje de instituciones con infraestructura y equipamiento inadecuado era de 96%, con rangos que llegaban al 100% en establecimientos de 16 regiones: Amazonas, Apurímac, Arequipa, Cajamarca, Callao, Cusco, Huancavelica, Huánuco, Lambayeque, Lima, Loreto, Madre de Dios, Pasco, Piura, Tacna y Ucayali.
Luis Lazo Valdivia, coordinador nacional de la organización civil ForoSalud y miembro del Consejo Nacional de Salud, recordó que la vigilancia epidemiológica es clave para la reducción de IAAS. "Lo que está sucediendo ahora es un incremento relativo de las infecciones que, habitualmente, ocurren. Las neumonías vinculadas al uso de respiradores son los casos que más se están dando", dijo.
Las tasas de incidencia —que miden el número de personas que contraen una enfermedad durante un determinado período—, por ejemplo, sirven para determinar si en un establecimiento de salud se está presentando un brote. Esto ocurre cuando sobrepasan los valores del promedio nacional, explicó César Munayco Escate.
La información obtenida por OjoPúblico no permite un análisis tan detallado. Sin embargo, al examinar la evolución de la tasa de incidencia promedio en el ámbito nacional sí se observa un crecimiento de este indicador en algunos dispositivos médicos de las áreas de hospitalización de EsSalud y el Minsa, desde que empezó la pandemia.
En 2019, por ejemplo, la tasa media de neumonía asociada al uso de ventilador mecánico en los establecimientos del Minsa era de 7. Sin embargo, en 2021, llegó a 13,33, y, en 2022, fue de 9,04, de acuerdo a la información brindada por el ministerio.
En total, el año pasado, se presentaron 2.725 casos de bacterias adquiridas por usuarios de ventiladores. Si bien los riesgos son mayores para pacientes en UCI, estas infecciones representaron el 46,29% del global de casos de IAAS (5.887) del 2022 para Perú.
En Essalud se observa una tendencia similar. En 2019, la tasa media de neumonía asociada al uso de ventilador mecánico en las UCI de los establecimientos de salud de nivel IV fue de 13,60; mientras que, en 2022, esta alcanzó 20,50.
Incremento de casos
El 20 de setiembre de 2021, Silvia Mamani Mamani dio a luz a Andrea, en la posta Maritza Campos, de la ciudad de Arequipa. La bebé nació con una insuficiencia cardíaca. Cuando su salud empeoró, relató su madre a OjoPúblico, la trasladaron al área de neonatología del Hospital Goyeneche, en la capital de la región.
En ese área, la menor permaneció un mes y, luego, fue trasladada a la zona de pediatría. Según Mamani Mamani, el trato del personal médico cambió cuando ella acudió a los medios de comunicación para pedir que se gestionará su traslado a Lima: la pequeña requería ser operada del corazón por la insuficiencia con la que nació.
Luego de hacer pública esta situación, afirmó, los médicos le daban información escasa sobre el estado de salud de Andrea y la trasladaron a un área más hacinada, donde había casos de menores con neumonía intrahospitalaria.
“Una vez que hice público el hecho [el pedido de traslado a Lima], ahí es donde la doctora jefa del servicio cambió su trato. Un día le pregunté cómo amaneció mi hija, me dijo que estaba bien, y se fue sin darme más explicaciones. Yo me di cuenta ahí y, luego, una de las enfermeras me lo confirmó, porque me dijo: ‘eres tú la que ha ido a hacer público, has dicho que en el Hospital Goyeneche te están dando un mal trato’”, contó.

VIGILANCIA. La limpieza permite la reducción del contagio de patógenos.
Foto: Minsa.
Al cabo de dos meses, su bebé falleció. Silvia Mamami Mamani cree que el de su hija es uno de los múltiples casos de IAAS que no constan formalmente en los registros del país. En opinión de Celis Salinas, el subregistro de contagios y decesos por esta causa es un problema sin resolver: hay poca información previa al último quinquenio y, durante la pandemia, se hizo un cambio normativo que todavía se viene implementando.
Munayco Escate, por su parte, aseguró que el incremento en la estadística de muertes y contagios de los últimos años se debe al sinceramiento de las cifras y a la implementación de más UCI en distintos hospitales.
El especialista del CDC —una institución que depende del Minsa— contó que, este 2023, se realizará un estudio de prevalencia de las infecciones, que tiene el objetivo de identificar los casos subregistrados. La última vez que se hizo un análisis similar fue en 2021.
Este medio se comunicó con EsSalud, para solicitar una entrevista con algún vocero de la entidad. Sin embargo, la institución informó que no participaría de este informe periodístico.
De igual modo, se solicitó su descargo al Hospital Goyeneche, de Arequipa. La directora María Sotomayor Cabrera dijo que, como no es su especialidad y no se encontraba en el cargo cuando ocurrieron los hechos narrados por Silvia Mamani Mamani, no sabía del tema y, por lo tanto, no podía dar mayores precisiones. Señaló que las infecciones intrahospitalarias son comunes en todo el mundo y que, si había alguna queja contra el hospital, debía presentarse por mesa de partes.
La resistencia a los antimicrobianos y las IAAS
La OMS ha calificado a la resistencia a los antimicrobianos (RAM) como una pandemia silenciosa y un problema de salud pública que va en aumento. Esta resistencia ocurre cuando las bacterias, hongos y virus evolucionan para resistir a los antibióticos o desinfectantes. Se estima que las infecciones bacterianas resistentes provocan la muerte de cerca de 4,95 millones de personas al año en todo el mundo.
Juan Carlos Celis Salinas explica que muchas de estas bacterias resistentes infectan a los pacientes y pueden provocar brotes de IAAS. Al no ser sensibles a varios medicamentos, aumentan la posibilidad de muerte en los contagiados.
El 5 de marzo de 2022, el Minsa publicó la Norma Técnica de Salud para la Implementación del Programa de Optimización del Uso de Antimicrobianos (PROA) a nivel hospitalario, que tiene como objetivo reducir la incidencia de infecciones en centros de salud y optimizar el uso de estos medicamentos.

RIESGO. Personas conectadas a un ventilador en UCI tienen más riesgo de infecciones por bacterias intrahospitalarias.
Foto: EsSalud.
En el marco de la implementación de esta norma técnica, el pasado 10 de agosto, la Sociedad Peruana de Enfermedades Infecciosas y Tropicales, presidida por Celis Salinas, remitió una comunicación al Minsa, señalando que en Perú no se cuenta con medicamentos de última tecnología para hacer frente a patógenos resistentes.
En ese sentido, solicitaron que se apruebe un listado complementario de fármacos antimicrobianos que, hasta el momento, no están incluidos en el Petitorio Nacional Único de Medicamentos Esenciales del Sector Salud. Este documento técnico regula la adquisición y utilización de medicamentos en todos los establecimientos de salud.
Si bien la resistencia a estos fármacos es un fenómeno natural producido por los microorganismos, el proceso se puede acelerar por otros factores. La automedicación y el uso incorrecto de medicamentos —recordó el médico Luis Lazo Valdivia— contribuyen a la aparición de la resistencia a antimicrobianos.










